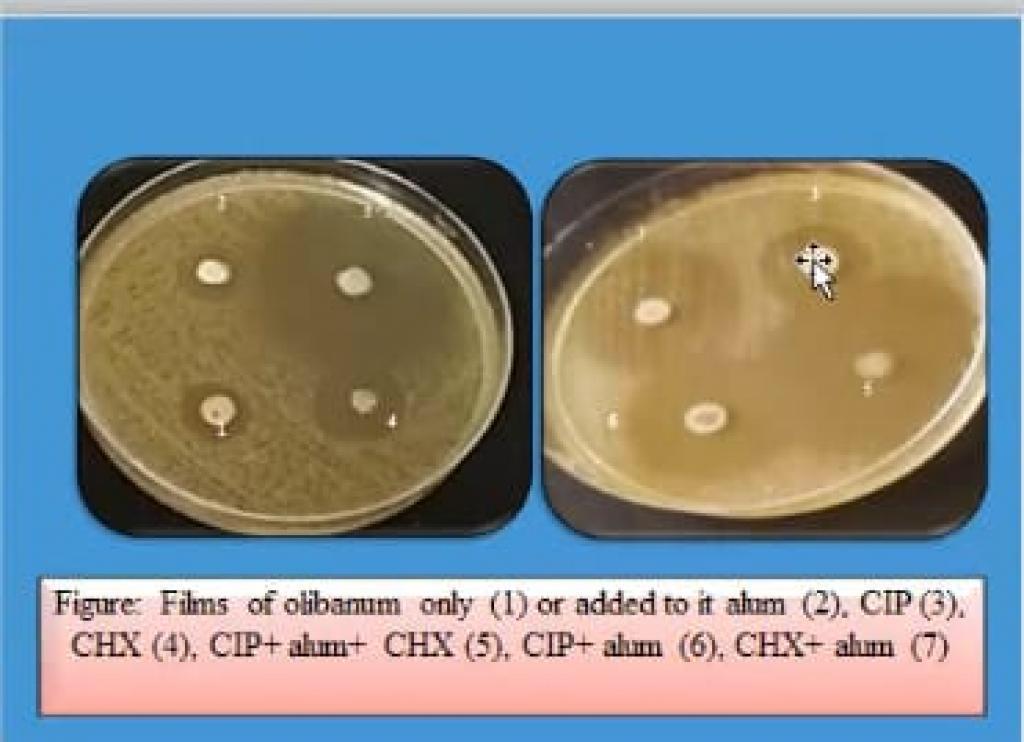

1 يوليو، 2021
كلية العلوم تقيم حلقة دراسية عن التأثير التأزري للمستخلصات النباتية ضد بعض الأنواع البكتيرية المرضية

اقامت كلية العلوم بجامعة الموصل وضمن سلسلة النشاطات العلمية حلقة دراسية عن التأثير التأزري للمستخلصات النباتية ضد بعض الأنواع البكتيرية المرضية وتقييم الفعالية الحيوية للمستخلص الطبيعي لنبتة Olibanum يوم الأربعاء الموافق 30 حزيران 2021 ، و عبر الفضاء الإلكتروني قدمتها الدكتورة سمية عدنان صالح .تناولت الحلقة التعريف عن فوائد المستخلصات النباتية و أهمية فعاليتها الحيوية ضد الأحياء المايكروبية المرضية .تطرقت الحلقة الى التركيز على المستخلص الحيوي لنبتة Olibanum و تأثيره التأزري مع بعض المضادات الحيوية ضد عزلات بكتيرية مريضة مقاومة للمضادات الحيوية من خلال عرض نتائج و أدلة واعدة لمثل هذا النوع من المستخلص الحيوي.شهدت الحلقة مشاركة فعالة لمجموعة من الأسئلة والاستفسارات في هذا المجال .